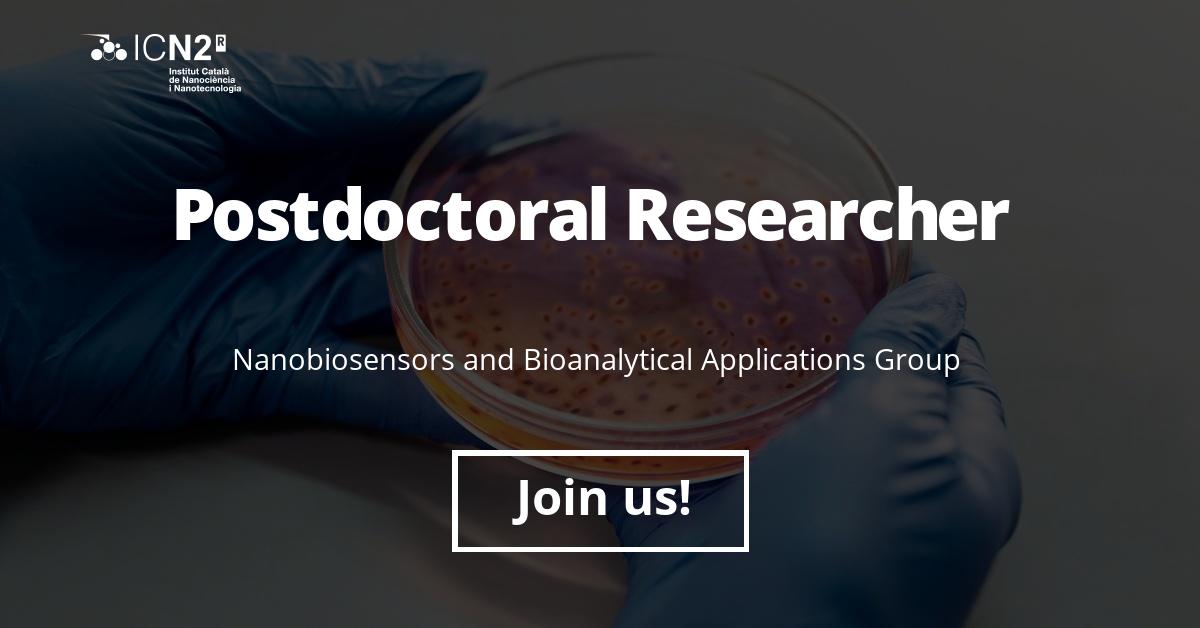

Maria Soler
@maria_soaz
Researcher. Nanotechnology for Biomedicine.
Valenciana en Barcelona. Dolça Diàspora.
ID: 254168457
18-02-2011 19:04:43
186 Tweet
278 Takipçi
337 Takip Edilen

Thanks to Catalan Institute of Nanoscience & Nanotechnology for this great opportunity. Let's #DANCE! 🧑🏽🔬💃


Moltes gràcies a Ajuntament de Barcelona i Fundación ”la Caixa” per donar suport al nostre projecte #DIGITS, per facilitar el cribatge poblacional d'ITS amb nanotecnologia òptica. Coordinat des del NanoB2A group Catalan Institute of Nanoscience & Nanotechnology, en col·laboració amb Vall d'Hebron i Centre Jove d'Atenció a les Sexualitats (Cjas) ⏭️

El projecte de Maria Soler que proposa un diagnòstic d'infeccions de transmissió sexual amb #nanotecnologia òptica ha rebut una #subvenció de l'Ajuntament de Barcelona i la Fundació ”la Caixa”. Enhorabona! 🤝Iniciativa en #col·laboració amb Vall d'Hebron Institut de Recerca i el Centre Jove d'Atenció a les Sexualitats (Cjas)




📣 WE'RE HIRING! 🔶 The NanoB2A group, led by Laura M. Lechuga Gom, is looking for a 𝐏𝐨𝐬𝐭𝐝𝐨𝐜𝐭𝐨𝐫𝐚𝐥 𝐑𝐞𝐬𝐞𝐚𝐫𝐜𝐡𝐞𝐫. 🎯 Apply here! jobs.icn2.cat/job-openings/6… 🌐 Or please share with your connections! #JobOffer #PostDoc #Nanobiosensors

A pleasure to be part of the Catalan Institute of Nanoscience & Nanotechnology Women Talent Program, and to have the opportunity to share my research, career experience and future perspectives! NanoB2A group CIBER-BBN CSIC BIST-Barcelona Institute of Science and Technology

📢 We're HIRING! We are looking for an EXPERIENCED #engineer with knowledge in optics instrumentation, microfluidics and software development, to join us in a #TechTransfer project. ➡️jobs.icn2.cat/job-openings/6… And please, help us spread the word with RT! 🔄 Catalan Institute of Nanoscience & Nanotechnology CSIC Centres CERCA


Our new publication! Check it out here: link.springer.com/article/10.100… #labelfree #nanoplasmonics #biosensor #chechkpointinhibtors #immunotherapy #biomimetics NanoB2A group Catalan Institute of Nanoscience & Nanotechnology

We are deeply honored to contribute to the Anal Bioanal Chem Special Issue dedicated to the memory of our esteemed Prof. M. Cruz Moreno Bondi. You can check out our latest publication on #biomimetic #sensors here! 🔽🔽 link.springer.com/article/10.100…


🔬 PhD THESIS DEFENCE 🔹Student: Bárbara Lisboa, from the NanoB2A group 🔹Directors: Dr César Moreno, Dr Maria Soler 📆 Friday, 31st Oct. ⏰ 11 AM 📍 ICN2 Seminar Room 📝 Register at 👉 forms.office.com/e/zzkDRCV1w3 🍀 Good luck, Bárbara! #SiliconPhotonics #Graphene #ICN2PhD

My very first PhD student getting her PhD title... After such a challenging journey, it is very well deserved! So happy to have shared with you these 4 years, and wish you all the best for the future! Congrats, Bárbara! Bárbara Lisboa

My warmest congrats to razia batool for her PhD! Your hard work, resilience, and eagerness to learn have been truly impressive. Supporting and watching you grow into a brilliant researchers has been a real pleasure. #ProudSupervisor #NewPhD

📅 El 16/11 se celebró #BCNspiracy en Museu de la Ciència CosmoCaixa acercando la ciencia al público. Del ICN2, participaron: 🔹 Dra. Mary Cano-Sarabia: micro y #nanoencapsulación 🔹 Dra. Maria Soler biosensores ópticos 🔹 Dr. Giulio Rosati: biosensores sostenibles ¡Charlas muy interesantes! 👏


#ASCOS is coming! 👀 pls, help spread the word 🗣️ Catalan Institute of Nanoscience & Nanotechnology CSIC Optica ACS Sensors Anal Bioanal Chem ACS Analytical Chemistry Journals BIST-Barcelona Institute of Science and Technology SEDOPTICA

Join us at ASCOS2025! If you are an early researcher interested in Optical Chemical Sensors, do not miss this fantastic summer school. Pre-registration is now open: forms.office.com/e/PGuLR7WxNW. For further information: ascos.org or by email [email protected]
